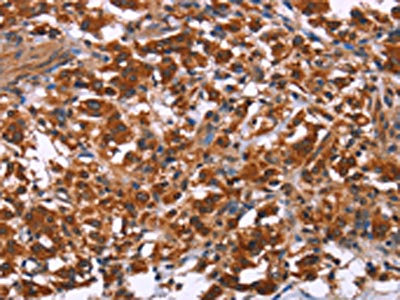

ING2 Antibody
-
中文名稱:ING2兔多克隆抗體
-
貨號:CSB-PA777986
-
規(guī)格:¥1100
-
圖片:
-
The image on the left is immunohistochemistry of paraffin-embedded Human thyroid cancer tissue using CSB-PA777986(ING2 Antibody) at dilution 1/40, on the right is treated with fusion protein. (Original magnification: ×200)
-
The image on the left is immunohistochemistry of paraffin-embedded Human liver cancer tissue using CSB-PA777986(ING2 Antibody) at dilution 1/40, on the right is treated with fusion protein. (Original magnification: ×200)
-
Gel: 10%SDS-PAGE, Lysate: 40 μg, Lane 1-3: Lovo cells, human liver cancer tissue, mouse kidney tissue, Primary antibody: CSB-PA777986(ING2 Antibody) at dilution 1/425, Secondary antibody: Goat anti rabbit IgG at 1/8000 dilution, Exposure time: 40 seconds
-
-
其他:
產(chǎn)品詳情
-
Uniprot No.:
-
基因名:ING2
-
別名:ING 1 like tumor suppressor protein antibody; ING 1L antibody; ING 2 antibody; ING1 like tumor suppressor protein antibody; ING1L antibody; ING1Lp antibody; ING2 antibody; ING2_HUMAN antibody; Inhibitor of growth 1 like antibody; Inhibitor of growth 1 like protein antibody; Inhibitor of growth 1-like protein antibody; Inhibitor of growth family member 1 like antibody; Inhibitor of growth family member 2 antibody; Inhibitor of growth protein 2 antibody; p32 antibody; p33 ING2 antibody; p33ING2 antibody
-
宿主:Rabbit
-
反應種屬:Human,Mouse
-
免疫原:Fusion protein of Human ING2
-
免疫原種屬:Homo sapiens (Human)
-
標記方式:Non-conjugated
-
抗體亞型:IgG
-
純化方式:Antigen affinity purification
-
濃度:It differs from different batches. Please contact us to confirm it.
-
保存緩沖液:-20°C, pH7.4 PBS, 0.05% NaN3, 40% Glycerol
-
產(chǎn)品提供形式:Liquid
-
應用范圍:ELISA,WB,IHC
-
推薦稀釋比:
Application Recommended Dilution ELISA 1:2000-1:5000 WB 1:500-1:2000 IHC 1:50-1:200 -
Protocols:
-
儲存條件:Upon receipt, store at -20°C or -80°C. Avoid repeated freeze.
-
貨期:Basically, we can dispatch the products out in 1-3 working days after receiving your orders. Delivery time maybe differs from different purchasing way or location, please kindly consult your local distributors for specific delivery time.
-
用途:For Research Use Only. Not for use in diagnostic or therapeutic procedures.
相關產(chǎn)品
靶點詳情
-
功能:Seems to be involved in p53/TP53 activation and p53/TP53-dependent apoptotic pathways, probably by enhancing acetylation of p53/TP53. Component of a mSin3A-like corepressor complex, which is probably involved in deacetylation of nucleosomal histones. ING2 activity seems to be modulated by binding to phosphoinositides (PtdInsPs).
-
基因功能參考文獻:
- The ING1L gene may be involved in basal cell carcinogenesis. PMID: 15005689
- P33ING2 cooperates with p53 to regulate apoptosis via activation of both the mitochondrial/intrinsic and death-receptor/extrinsic apoptotic pathways. PMID: 15748897
- ING2 can act as a cofactor of p300 for p53 acetylation and thereby plays a positive regulatory role during p53-mediated replicative senescence. PMID: 16024799
- The expression of ING2 was down-regulated in 6 of 7 lung cancer cell lines that had a p53 mutation. PMID: 16465410
- Observations suggest that p33ING2 is required for the initial DNA damage sensing and chromatin remodeling in the nucleotide excision repair process. PMID: 16488987
- The data showed that nuclear ING2 expression was significantly reduced in radial growth phase (RGP), vertical growth phase (VGP), and metastatic melanomas compared with dysplastic nevi (P < 0.05). PMID: 16755297
- Deletion of leucine zipper-like (LZL)abrogated the association between ING2 and p53, suggesting that ING2 modulates p53-dependent chromatin remodeling, apoptosis and DNA repair. PMID: 16782091
- molecular modeling and docking of the 5-methylenephosphonate or 5-phosphothionate analogues to the C-terminus PtdInsP-binding region of ING2 revealed a number of complementary surface and electrostatic contacts between the lipids and ING2 PMID: 17469822
- p33ING2/ING1L is a DNA damage-inducible gene that negatively regulates cell proliferation through activation of p53 by enhancing its acetylation. PMID: 11481424
- Our findings provide evidence for a novel crosstalk and a crossregulation between ING1 and ING2 in regulating androgen receptor-mediated transactivation and suggest that ING2 acts as a novel corepressor that inhibits AR signaling, prostate cancer cell growth, and migration. PMID: 27305909
- ING2 may be involved in the repair and regeneration of organs or tissues and is associated with breast and gynecological carcinogenesis. PMID: 26717876
- Results suggest that ING2 acts as a tumor suppressor in osteosarcoma. PMID: 25190103
- It is thought that ING2 gene expression level could contribute to the development of BCC but not be associated with the stage and the prognosis of the tumor. PMID: 25613071
- Decreased expression of ING2 gene is associated with non-small cell lung cancer. PMID: 24712846
- It was concluded that ING2 not only plays an essential role in the growth and invasion of MGC-803 cells but also represents a potential approach to chemosensitization therapy in human gastric cancer. PMID: 23864195
- findings support a model in which PtdIns(5)P functions as a sub-nuclear trafficking factor that stabilizes ING2 at discrete genomic sites PMID: 23823870
- Study establishes ING2 as a novel regulator of spermatogenesis functioning, and provides an animal model to study idiopathic and iatrogenic infertility in men. PMID: 21124965
- Data show that inhibition of ING2 expression accelerates progression of cells from G(1) to S-phase, and is accompanied by a decrease of p21 expression, and that regulation of p21 by ING2 is independent of p53. PMID: 20890119
- expression is downregulated in non-small cell lung carcinoma PMID: 19962781
- sumoylation of ING2 enhances its binding to the Sin3A/HDAC complex and is required to regulate gene transcriptions PMID: 20676127
- Decreased expression of ING2 gene is associated with hepatocellular carcinoma PMID: 18160212
- ING2 collaborates with SnoN to mediate TGF-beta-induced Smad-dependent transcription and cellular responses PMID: 18334480
- p53-mediated mir34a, mir34b, and mir34c up-regulation and ING2 down-regulation may be involved in the senescence pathway. PMID: 18451145
- ING2 C-terminus recruits histone methyltransferase activity, which correlates with silencing function PMID: 18513492
- ING2a knockdown suppressed cell growth only in the presence of p53, ING2b knockdown had no effect on cell growth, and knockdown of both induced cell cycle arrest and apoptosis independently of p53. PMID: 18951897
- ING2 loss of heterozygosity is associated with advanced staging in head and neck squamous cell carcinoma and determines survival rate. PMID: 18998165
- ING2 is upregulated in colon cancer and increases invasion by enhanced MMP13 expression. PMID: 19437536
- found that ING2 interacts with proliferating cell nuclear antigen and regulates its amount to the chromatin fraction, allowing normal replication progression and normal cell proliferation. PMID: 19730436
顯示更多
收起更多
-
亞細胞定位:Nucleus. Note=Predominantly nuclear. Localized to chromatin and nuclear matrix. Upon reduced PtdIns(5)P levels seems to be released from chromatin and, at least partially, translocated to the cytoplasm.
-
蛋白家族:ING family
-
組織特異性:Widely expressed. Higher expressed in colon-cancer tumor than in normal colon tissues.
-
數(shù)據(jù)庫鏈接:
Most popular with customers
-
-
YWHAB Recombinant Monoclonal Antibody
Applications: ELISA, WB, IHC, IF, FC
Species Reactivity: Human, Mouse, Rat
-
Phospho-YAP1 (S127) Recombinant Monoclonal Antibody
Applications: ELISA, WB, IHC
Species Reactivity: Human
-
-
-
-
-